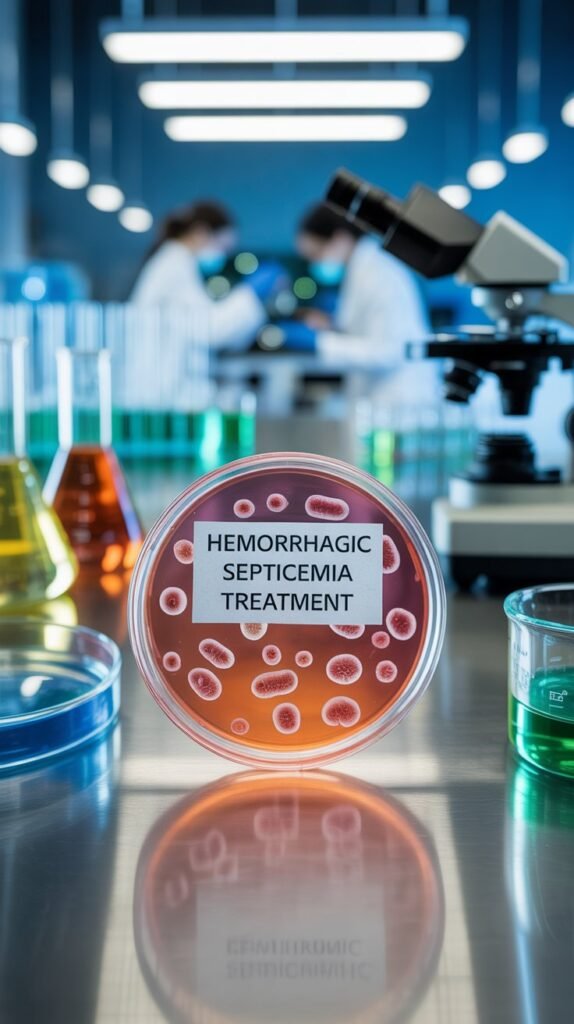
Hemorrhagic Septicemia Treatment

Hemorrhagic Septicemia is one of the most concerning bacterial diseases affecting both aquaculture and livestock industries worldwide. It is caused by pathogenic strains of Pasteurella multocida and in some cases other opportunistic bacteria. In fish, it is often associated with Aeromonas hydrophila, while in cattle and buffalo, it is primarily linked to specific serotypes of Pasteurella multocida. The disease is characterized by sudden onset, rapid progression, high mortality, and extensive hemorrhages in internal organs. For farmers, aquarists, and veterinarians, timely diagnosis and treatment of hemorrhagic septicemia are critical for minimizing losses and maintaining animal health.
This article provides a comprehensive look at hemorrhagic septicemia treatment, including traditional methods, modern therapeutic strategies, preventive measures, and supportive care. Whether you are dealing with outbreaks in fish farms, aquariums, or livestock herds, understanding the treatment options can make a significant difference in survival rates and long-term health outcomes.
Understanding Hemorrhagic Septicemia
What is Hemorrhagic Septicemia?
Hemorrhagic Septicemia (HS) is an acute, septicemic bacterial infection that causes internal bleeding, high fever, swelling, and sudden death in animals. In aquaculture, the disease is particularly devastating as it spreads quickly in overcrowded ponds or aquariums, especially when water quality is poor. In livestock, outbreaks often occur seasonally, particularly during hot and humid conditions.
Causative Agents
- Livestock: Pasteurella multocida serotypes B:2 and E:2 are the primary pathogens.
- Fish: Aeromonas hydrophila, Vibrio anguillarum, and sometimes Pseudomonas species contribute to septicemia.
- Poultry: Certain strains of Pasteurella multocida can also cause fowl cholera with septicemia-like symptoms.
Symptoms in Fish
- Erratic swimming and lethargy
- Hemorrhages on fins, gills, and abdomen
- Swollen body with fluid accumulation
- Ulcers and open wounds on the skin
- High mortality in crowded or stressed conditions
Symptoms in Livestock
- High fever (105–107°F)
- Severe depression and drooling
- Swelling in the throat, brisket, and lower body
- Rapid breathing and nasal discharge
- Sudden death within 12–24 hours if untreated
Hemorrhagic Septicemia Treatment in Fish
1. Antibiotic Therapy
Antibiotics are the frontline treatment for bacterial hemorrhagic septicemia in aquaculture. However, they must be used responsibly to avoid resistance.
- Oxytetracycline: Widely used in medicated feed or as a bath treatment.
- Enrofloxacin: Effective against Aeromonas and other pathogens in fish.
- Florfenicol: Preferred in cases where resistance is observed.
- Sulfonamides and Trimethoprim Combinations: Used in feed to treat septicemia.
Note: Always follow veterinary guidance for dosage and withdrawal periods, especially in food fish.
2. Salt Baths and Supportive Care
Short-term salt baths (2–3% concentration) help reduce stress and external bacterial load. They are not a cure but support recovery alongside antibiotics.
3. Herbal and Natural Remedies
Some fish farmers prefer herbal treatments as preventive or supportive measures:
- Garlic extract: Known for antimicrobial properties.
- Turmeric: Anti-inflammatory and antibacterial benefits.
- Aloe vera: Promotes wound healing.
4. Improving Water Quality
Since water quality plays a major role in disease outbreaks, treatment should always be paired with environmental correction:
- Reduce ammonia and nitrite levels
- Increase aeration
- Perform partial water changes
- Remove dead or infected fish immediately
Hemorrhagic Septicemia Treatment in Livestock

1. Antibiotics and Veterinary Drugs
Livestock treatment requires immediate intervention because HS progresses very rapidly. Commonly used drugs include:
- Tetracyclines (Oxytetracycline, Doxycycline): Effective in acute cases.
- Sulfonamides: Long-acting sulfa drugs combined with trimethoprim show good results.
- Ceftiofur: A modern broad-spectrum antibiotic effective against Pasteurella.
- Gentamicin and Streptomycin: Often used in combination therapies.
- Enrofloxacin: Effective in controlling septicemia in cattle and buffalo.
Veterinarians typically administer antibiotics via intramuscular or intravenous routes for rapid absorption.
2. Anti-inflammatory and Supportive Care
- NSAIDs (Flunixin Meglumine, Ketoprofen): Reduce fever, swelling, and pain.
- Fluid therapy: To combat dehydration and septic shock.
- Vitamin supplementation: Enhances immune response.
3. Early Intervention
Since mortality can occur within hours, immediate recognition and treatment are vital. Animals showing early signs such as fever, swelling, and nasal discharge must be treated without delay.
Preventive Strategies
Treatment is essential, but prevention remains the most cost-effective and sustainable strategy.
In Fish Farming
- Maintain optimal stocking density to reduce stress.
- Regular water testing and filtration.
- Balanced diet with immune-boosting additives.
- Quarantine new fish before introducing them into the main tank or pond.
- Vaccines are being developed for some fish species against Aeromonas infections.
In Livestock
- Vaccination: Annual vaccination against hemorrhagic septicemia is the most effective preventive measure. Oil-adjuvant and alum-precipitated vaccines are widely available.
- Good husbandry practices: Proper nutrition, shelter, and stress management reduce susceptibility.
- Avoid overcrowding: Overcrowded pens increase the risk of outbreaks.
- Seasonal preparedness: Outbreaks often occur during rainy and humid seasons; vaccinate before these periods.
Challenges in Hemorrhagic Septicemia Treatment
Antibiotic Resistance
Overuse of antibiotics in aquaculture and livestock has led to resistant strains of Pasteurella and Aeromonas. Farmers should avoid indiscriminate use of antibiotics and rely on veterinary prescriptions.
Diagnosis
Accurate diagnosis is essential before treatment. Laboratory tests such as bacterial cultures, PCR, and serological tests help confirm the presence of Pasteurella multocida or other pathogens.
Economic Burden
Outbreaks cause huge financial losses due to high mortality rates, treatment costs, and reduced productivity. Investing in prevention and vaccination is more economical than treating repeated outbreaks.
Role of Modern Biotechnology in Treatment

Vaccines for Aquaculture
New-generation vaccines are being researched to provide long-lasting immunity in fish. DNA vaccines and recombinant protein vaccines show promising results against Aeromonas hydrophila.
Immunostimulants
Substances like beta-glucans, probiotics, and herbal extracts are being used to boost the innate immunity of fish and livestock, making them more resistant to septicemia.
Rapid Diagnostic Kits
Point-of-care diagnostic kits are now available for quick field detection of HS pathogens, allowing farmers to start treatment sooner.
Step-by-Step Guide for Farmers
In Fish
- Identify early symptoms: hemorrhages, ulcers, lethargy.
- Isolate sick fish to reduce spread.
- Treat with appropriate antibiotics under veterinary guidance.
- Improve water quality immediately.
- Use salt baths or herbal supplements for supportive care.
In Livestock
- Watch for early signs: fever, swelling, respiratory distress.
- Call a veterinarian immediately.
- Start antibiotic injections without delay.
- Provide anti-inflammatory drugs to reduce stress.
- Ensure hydration and supportive care.
- Vaccinate all healthy animals after outbreak control.
Conclusion
Hemorrhagic Septicemia is a fast-acting and deadly bacterial disease affecting fish, livestock, and sometimes poultry. While effective treatments exist in the form of antibiotics, supportive care, and environmental management, prevention through vaccination, good husbandry, and biosecurity is the ultimate safeguard. For fish farmers and livestock owners, staying vigilant, maintaining hygiene, and seeking veterinary advice promptly can save lives and protect livelihoods.
FAQs on Hemorrhagic Septicemia Treatment
Q1. What is the best antibiotic for hemorrhagic septicemia?
Oxytetracycline, ceftiofur, and enrofloxacin are commonly used, but the best choice depends on the species affected and bacterial resistance patterns. Always consult a veterinarian before use.
Q2. Can hemorrhagic septicemia be cured?
Yes, if detected early and treated with the right antibiotics and supportive care, animals can recover. However, in advanced cases, mortality is very high.
Q3. How do you prevent hemorrhagic septicemia in livestock?
The most reliable method is annual vaccination before high-risk seasons, along with good nutrition, hygiene, and avoiding overcrowding.
Q4. How do you treat hemorrhagic septicemia in fish?
Treatment involves medicated feed containing antibiotics, salt baths, water quality management, and isolation of sick fish.
Q5. Is hemorrhagic septicemia contagious?
Yes, it spreads rapidly in crowded environments, either through direct contact, contaminated water, or secretions from infected animals.
Q6. Are herbal remedies effective for treating hemorrhagic septicemia?
Herbal remedies such as garlic and turmeric can support treatment but should not replace antibiotics in severe cases.
Q7. Can humans get hemorrhagic septicemia?
While Pasteurella multocida can occasionally infect humans through animal bites or contact, the typical livestock or fish strains of hemorrhagic septicemia rarely affect humans.
Q8. Why is early treatment important?
Because hemorrhagic septicemia progresses very quickly, untreated animals can die within hours to a few days. Early antibiotic intervention dramatically improves survival rates.

